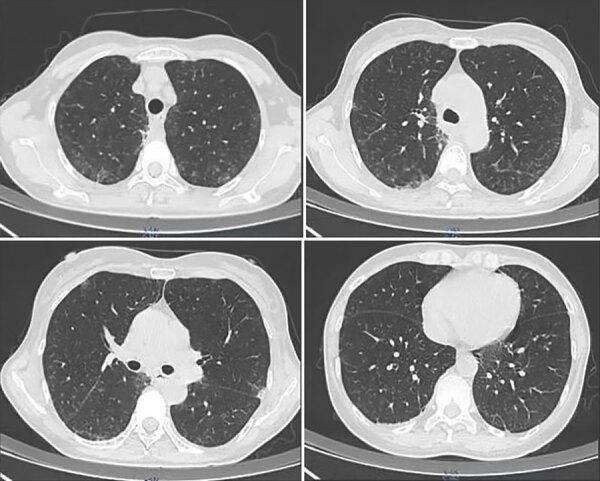
https://cdn.ncbi.nlm.nih.gov/pmc/blobs/d2cb/11346996/2f475397ba89/24-0615-F1.jpg

非 HIV 免疫功能健全的 COVID-19 患者合并严重肺孢子菌肺炎感染。
Non-HIV Immunocompetent Patient with COVID-19 and Severe Pneumocystis jirovecii Pneumonia Co-Infection.
出版信息
Emerg Infect Dis. 2024 Sep;30(9):1948-1952. doi: 10.3201/eid3009.240615.
Abstract
Pneumocystis jirovecii pneumonia is an opportunistic infection that affects HIV-infected and immunocompromised persons and rarely affects immunocompetent patients. However, after the advent of the COVID-19 pandemic, some COVID-19 patients without immunocompromise or HIV were infected with P. jirovecii. Clinical manifestations were atypical, easily misdiagnosed, and rapidly progressive, and the prognosis was poor.
摘要
肺孢子菌肺炎是一种机会性感染,影响 HIV 感染者和免疫功能低下者,很少影响免疫功能正常的患者。然而,在 COVID-19 大流行出现后,一些没有免疫抑制或 HIV 的 COVID-19 患者感染了肺孢子菌。临床表现不典型,容易误诊,病情进展迅速,预后不良。